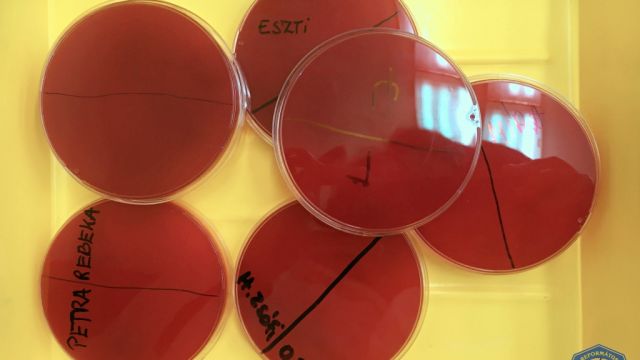

A 11-es biológia fakultációsokkal szerdán az Állatorvostudományi Egyetem Járványtani és Mikrobiológiai Tanszékén jártunk.
Dr. Tóth Gergely lónyays öregdiák vezetésével – aki az egyik tanszéki állatorvos – egy bakteriológiai gyakorlaton vehettünk részt! Gergő 2005-ben végzett a Lónyayban.
Hálásan köszönjük ezúton is Neki a lehetőséget, hogy az egyetemi laborban széleszthettük, olthattuk, festhettük, a véres agaron általa előre kitenyésztett baktériumtelepeket. Nagyon sokat tanultunk a 3 órás gyakorlaton, melyen többek között leolthattuk a saját száj és kézflóránkat is, és több bakteriológiai-mikrobiológiai technológiával megismerkedhettünk!
További beszámoló: https://univet.hu/hu/2020/02/14/kozepiskolasoknak-szervezett-bakteriologia-gyakorlatot-a-jarvanytani-es-mikrobiologiai-tanszek/

Pályázati forrás bevonásával valósult meg a gimnázium felújítása.
Pályázati forrás bevonásával valósult meg a gimnázium felújítása.








